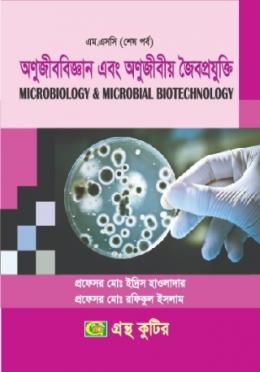

অণুজীব বিজ্ঞান এবং অনুজীবীয় জৈবপ্রযুক্তি (মাস্টার্স ফাইনাল ইয়ারের টেক্সট বই)
(0 reviews)
Price:
৳335
/Pc
Share:
Top Selling Products
বইয়ের বিবরণী
বইয়ের নাম: অণুজীব বিজ্ঞান এবং অনুজীবীয় জৈবপ্রযুক্তি (মাস্টার্স ফাইনাল ইয়ারের টেক্সট বই)
লেখক: প্রফেসর মো ইদ্রিস হাওলাদার,প্রফেসর মো রফিকুল ইসলাম
বিভাগ/ শ্রেণী: মাস্টার্স শেষ বর্ষ
There have been no reviews for this product yet.





















